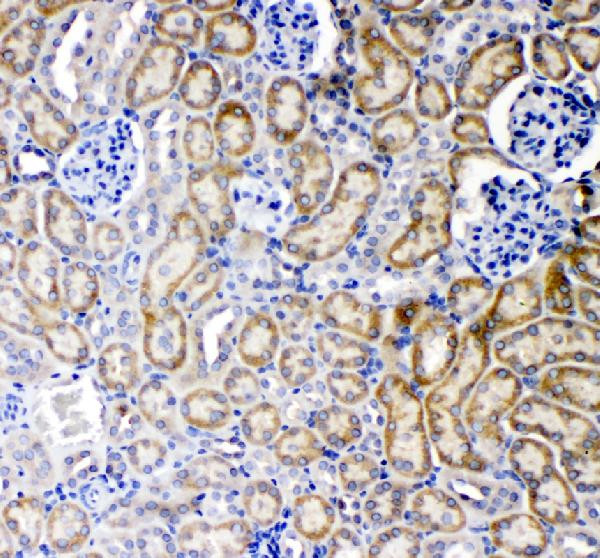
TNFR1 Antibody in Immunohistochemistry (Paraffin) (IHC (P))

Search
Invitrogen
TNFR1 Polyclonal Antibody
{{$productOrderCtrl.translations['antibody.pdp.commerceCard.promotion.promotions']}}
{{$productOrderCtrl.translations['antibody.pdp.commerceCard.promotion.viewpromo']}}
{{$productOrderCtrl.translations['antibody.pdp.commerceCard.promotion.promocode']}}: {{promo.promoCode}} {{promo.promoTitle}} {{promo.promoDescription}}. {{$productOrderCtrl.translations['antibody.pdp.commerceCard.promotion.learnmore']}}
图: 1 / 4
TNFR1 Antibody (PA5-95585) in IHC (P)




Please note: We are reviewing Western blot images included in the antibody testing data in our catalog, including those provided by third parties. Unless expressly labeled or annotated as “raw-unedited”, Western blot images included in the antibody testing data in our catalog may have been edited, optimized or otherwise adjusted for presentation.
产品信息
PA5-95585
种属反应
宿主/亚型
分类
类型
抗原
偶联物
形式
浓度
规格
纯化类型
保存液
内含物
保存条件
运输条件
RRID
产品详细信息
Reconstitute with 0.2 mL of distilled water to yield a concentration of 500 µg/mL.
Positive Control - WB: human Hela whole cell, human A549 whole cell, rat brain tissue, rat lung tissue, mouse brain tissue, mouse lung tissue. IHC: mouse colon tissue, mouse kidney tissue.|Store at -20°C for one year from date of receipt. After reconstitution, at 4°C for one month. It can also be aliquotted and stored frozen at -20°C for six months. Avoid repeated freeze-thaw cycles.
靶标信息
TNFR1 (Tumor necrosis factor receptor 1) belongs to the tumor necrosis factor superfamily, and is one of the major TNF-alpha receptors. TNFR1 plays an important role in mediating, in cytokine mediated signaling, positive regulation of the NF-Kb pathway, positive regulation of angiogenesis, and negative regulation of gene expression. The extracellular domain of TNFR1 is also released into the circulatory system as soluble TNFR1 (sTNFR1). In humans, the TNFR1 gene is located on chromosome 12. Anti-apoptotic protein BCL2-associated athanogene 4 (BAG4/SODD) and adaptor proteins TRADD and TRAF2 have been shown to interact with TNFR1, and thus play regulatory roles in the signal transduction mediated by the receptor. Germline mutations of the extracellular domains of TNFR1 were found to be associated with the autosomal dominant periodic fever syndrome, and the impaired receptor clearance is thought to be a mechanism of the disease.
仅用于科研。不用于诊断过程。未经明确授权不得转售。
篇参考文献 (0)
生物信息学
蛋白别名: CD120a; CD120a antigen; MGC19588; n-smase activation assoc. factor; p55; p60; p62; p63; sCD120a; soluble CD120a; soluble TNFR1; sTNF RI; sTNFR I; sTNFR1; sTNFRI; TNF receptor alpha chain; TNF-alpha-R1; TNF-R1; TNF-RI; TNFR; TNFR I; TNFR-I; Tumor necrosis factor receptor; Tumor necrosis factor receptor 1; Tumor necrosis factor receptor superfamily member 1A; Tumor necrosis factor receptor type I
基因别名: CD120a; FPF; p55; p55-R; TNF-alphaR1; TNF-R; TNF-R-I; TNF-R1; TNF-R55; TNFalpha-R1; TNFAR; TNFR-1; Tnfr-2; Tnfr1; TNFR60; TNFRI; TNFRp55; Tnfrsf1a
UniProt ID: (Rat) P22934, (Mouse) P25118
Entrez Gene ID: (Rat) 25625, (Mouse) 21937